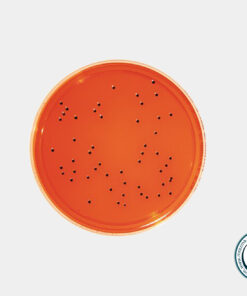
XLD آگار مرک کد 105287 \ فروشگاه اینترنتی مستر آزما

محیط کشت زایلوز لایزین دی اکسی کولات آگار مرک
زایلوز لایزین دی اکسی کولات آگار یک محیط انتخابی و افتراقی برای جداسازی، کشت و تمایز میکروارگانیسمهای گرم منفی روده و تمایز سالمونلا و شیگلا در نمونههای بالینی یا مواد غذایی است. فروش/خرید و قیمت به روز محیط کشت زایلوز لایزین دی اکسی کولات آگار یا زیلوز /لیزین/دزوکسی کولات آگار XLD مرک در فروشگاه مواد شیمیایی/آزمایشگاهی مسترآزما در بسته بندی اصلی شرکت سازنده (مرک-سیگما) امکان پذیر است.
برای اطلاعات بیشتر در مورد محیط کشتها و انواع آنها میتوانید به بخش مقالات سایت مقاله محیط کشت ها چه هستند؟ مراجعه کنید.
کاربردهای XLD آگار مرک
- برای جداسازی میکروارگانیسمهای گرم منفی روده
- آزمایشات میکروبیولوژیکی غذاها، آب و محصولات لبنی
- جهت جداسازی گونه های شیگلا و سالمونلا
- در آزمایشگاه های تشخیص طبی
مواد تشکیل دهنده محیط کشت زایلوز لایزین آگار
- لاکتوز
- ساکارز
- گزیلوز
- ال لیزین
- فنل رد
- دیوکسی کلات سدیم
- کلرید سدیم
- تیوزولفات سدیم
- آمونیوم فروت سیترات
- آگار
فروش زایلوز لایزین دی اکسی کولات آگار مرک کد 105287
فروشگاه مستر آزما به عنوان یکی از تامین کنندگان پیشگام محصولات شیمیایی و محیط های کشت از معتبرترین برندهای جهان آماده تامین و عرضه محیط کشت با کد 105287 با کیفیتی عالی و قیمتی رقابتی در مقادیر مختلف از کمپانی معتبر شرکت مرک – سیگما آلمان می باشد.
این کالا به همراه برگه آنالیز و ضمانت اصالت کالا به فروش می رسد.

دیدگاهها
هیچ دیدگاهی برای این محصول نوشته نشده است.